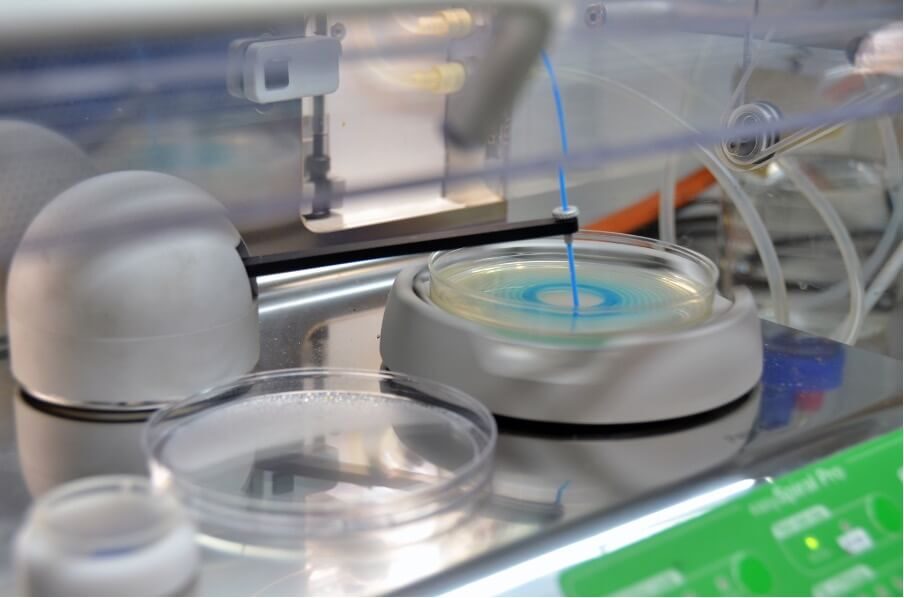
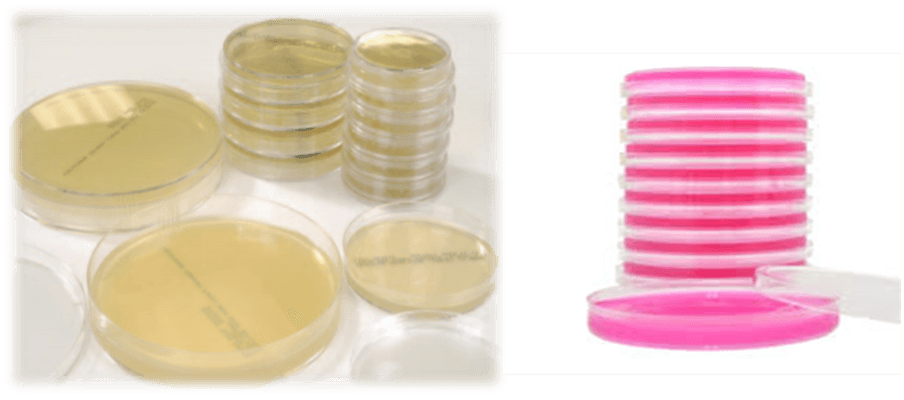

Your Sampling Guide
Introduction
The importance of food safety cannot be stressed enough, especially considering the detrimental effects of outbreaks of food-borne diseases. It is not only a health risk, but also causes economic losses and reputational damage. It is therefore important for food production facilities, from farm to fork, to realize the importance of keeping their facilities and products up to standard.
The most frequently asked question we, as laboratories, are asked is: “What and where do I need to test?”. Closely following this question is: “How do I sample?”. These are two of the most important aspects to consider when setting up a testing routine at your facility. Ensuring that samples are taken correctly is just as important as testing.
There are different types of testing that can be performed to ensure the best quality food reaches consumers, including:
- Final product testing (liquid or solid samples)
- Environmental monitoring
– Surface quality – surface swabs/contact paddles
– Air quality – air plates
– Water testing
– Personnel hygiene – hand swabs
The goals of sampling can vary significantly. Typical objectives of sampling for environmental data collection, specifically, are:
- To support a decision about whether contamination levels exceed a threshold of unacceptable risk.
- To identify the location of “hot spots” (areas having high levels of contamination).
- To characterize the nature and extent of contamination at a site.
- To monitor trends in environmental conditions or indicators of food safety.
Importance of Environmental Monitoring

The development of an effective environmental monitoring program should reflect a balance between employing the available resources efficiently and monitoring at sufficient intervals to ensure that a meaningful trend of the levels and nature of bacterial contamination can be obtained and resolved.
This article will discuss the correct sampling technique for each of the test types mentioned.
Final product testing
To sample final product the following procedure should be used:
- To ensure sample integrity, hands should be washed and sanitized before sampling commences.
- Have a cooler bag/box ready. Polystyrene cooler boxes are the most effective to transport samples to the appropriate laboratory.
- The use of a temperature probe is advised to record the temperature of the samples when sampling. The probe should be rinsed in sanitizing solution and dried with a clean disposable paper towel or a clean/sanitized cloth before inserting it into ethanol. The probe should be sterilized by dipping it into 95% ethanol and flaming it using a lighter. Place the probe in the sample and record the temperature.


- Depending on the sample type (for solid samples), use a sterile spoon, tongs, scissors, knife or other serving utensils (sterilized in the same manner as the temperature probe above) to obtain at least 200g of the product.
- Carefully place the sample into a sterile Ziploc fridge/freezer bag.
- For liquid samples, place 200ml of the sample directly into an appropriate container, e.g., red cap sample containers. Each red cap container can contain a maximum of 150ml liquid and if needed, more than one container should be filled.
- It is important to obtain an adequate sample size for all tests to be conducted. The laboratory can assist you with the needed sample size.
- It is important to determine your method of sampling, e.g., composite samples (samples taken from various locations, e.g., different carcasses or different bags of grain) or a sample from a single location (e.g., one carcass or one bag of grain).
- If a single location is used, it is important to note that a good representative of sample should be provided, e.g., various locations on one carcass or at varying depths of a bag of grain.
- Ensure that each sample bag/container is correctly labelled with a permanent marker. The sample description should be informative and should contain the contents and date.
- Place the samples into the cooler box with frozen icepacks as required. Keep in mind the duration of travel the samples will be subjected to.
Environmental monitoring and personnel hygiene: surface swabs and hand swabs
When taking surface swabs, it is important to ensure that the swabs are clearly labelled with the description of where the swab was taken and any other information about the conditions. It is also important to mark surface swabs and hand swabs clearly as such, to avoid confusion.
For surface swabs (Amie or sponge swabs), the following procedure should be followed:
- Unless otherwise specified (such as in the case of validation studies), surface swabs should be taken from visually clean surfaces.
- When using Amie swabs, a surface area of 10cm2 should be swabbed.
- Amie swabs should be used as follows (as indicated in the figures below):
- Remove the swab aseptically from plastic layer, ensuring not to touch the bud or any area of stem that will be returned into container.
- Insert swab into tube to moisten the cotton tip.
- Swab surface in multiple directions when sampling and ensure the swab is rotated between thumb and forefinger.
- After swabbing, the swab should be returned to the container and sealed carefully for transportation.
- Swabs should be kept inside the cooler box/bag with frozen ice bricks before and after sampling.
- Swabs should however not be in direct contact with the ice bricks, to avoid freezing of the gel.
- When using sponge swabs, a surface area of 10cm2, 20cm2 or 30cm2 should be swabbed.
- Sponge swabs should be used as follows (as indicated in the figures below):
- Open the plastic bag containing the sponge swab.
- Make sure the sponge is dipped in the liquid supplied in the plastic bag and that there is enough left to put it back in (the swab should be moist).
- Aseptically remove the sponge by using the blue plastic stick attached to it.
- Sample the chosen surface in two perpendicular directions, changing the face of the sponge.
- Aseptically return the swab to the bag.
- Break off the blue plastic stick and close the bag so that leakage is prevented.
- Swabs should be kept inside the cooler box/bag with frozen ice bricks before and after sampling.
- Swabs should however not be in direct contact with the ice bricks, to avoid freezing.

For hand swabs (Amie swabs), the following procedure should be followed:
- For hand swabs, the food handler/other relevant staff member shall wash their hands with anti-bacterial hand soap (and sanitize if applicable in the facility) before the swabs are taken.
- No hand swabs should be taken from persons who are responsible for cleaning (e.g., cleaners, staff working in a scullery/washing area) and who are handling cash.
- Ensure that the swabs are clearly marked as hand swabs to avoid confusion.
- The same procedure as for Amie surface swabs shall be used, however the surface to be swabbed will be the hands of personnel.
- Ensure that the swab is rubbed over the palm of the hand, between the fingers and across the nails.
- Swabs should be kept inside the cooler box/bag with frozen ice bricks before and after sampling.
- Swabs should however not be in direct contact with the ice bricks, to avoid freezing.
Environmental monitoring – Surfaces (using contact paddles)
Contact paddles can be used as an easy and effective way to monitor the surface quality for e.g., in hatcheries.
The following procedure should be used for sampling with contact paddles:
- Aseptically remove the plastic container from the contact paddle.
- Press the agar surface of the contact plate firmly and without any lateral movement against the test surface.
- Sample for 10 seconds (for optimum results, pressure obtained should be with a mass of 500 g.)

- Close the contact paddle as soon as possible and aseptically put it back in the container.
- Ensure that the contact paddle is labelled appropriately, considering that when the contact paddle lid shifts, the description will no longer pertain to side 1 or side 2. Therefore, include the side number in the description.
Environmental monitoring – Air quality
To determine the air quality air plates are used as follows:
- Determine the location where the samples will be taken.
- Clearly mark the plates on the bottom (side containing the media) and not on the lid.
- Open the supplied air plates and place on a surface on the same height from the ground as where normal activity within the facility would occur, e.g., on a conveyor belt or working table.
- Leave the air plates open for 15 minutes.
- Close the air plate and place in a cooler box/bag with frozen ice bricks.
- The air plates should not be direct contact with the ice bricks to avoid freezing of the media.
- Two types of media can be used for air plates – one for determining the total plate count and the other for determining yeast and moulds.
Environmental monitoring – Water
Water is used in various ways in facilities, be it for washing of carcasses or final rinse steps. It is important to use water of good quality.
Water sampling should be conducted as follows:
- Always take the sample from a cold-water tap.
- Flush the tap by running water (to waste) for 2 – 3 minutes, this will allow for adequate flushing of the pipe water between water main and tap.
- If the tap appears to be dirty, clean with sodium hypochlorite solution/ethanol, then allow the water to run for an additional 1 minute to rinse any remaining disinfectant.
- If red cap containers are used, remove the lid of the sample container with one hand. While holding the lid with one hand, fill the bottle with the other.
- Be careful not to touch the sides or inside lid of the bottle. Be careful not to touch the inside of the container. These measures will prevent samples from becoming contaminated.
- Ensure that a minimum of 100ml water is sampled for each test required. Keep in mind that red cap containers can respectively contain only 100ml or 150ml water (depending on size).
- If more than one test is required, ensure that more than one container is used for sampling.
- If using WHIRL-PAK sampling bags, the following procedure should be followed (as indicated by the figure below):
- Label your bag according to tap/borehole tank/area you’ll be sampling from.
- Tear off the top along the perforation.
- Use the Tyvec pull tabs to open without contamination.
- Allow water to run for 2 – 3 minutes prior, then collect water into bag ensuring it is not too full to spill out.
- Hold bag by the tabs and whirl 3 – 4 times to make a seal OR fold the bag over tightly 3 – 4 times to close.
- Secure closure by bending the wire ends or bring the two wire ends together and twist tie them.

We hope that this guide will aid you to take samples correctly in your facility.
For assistance, sampling and/or testing, please feel free to contact SMT LABS, SMT IMPROVE or SMT VETLAB. Let us walk with you on this journey of ensuring food safety for all consumers.



